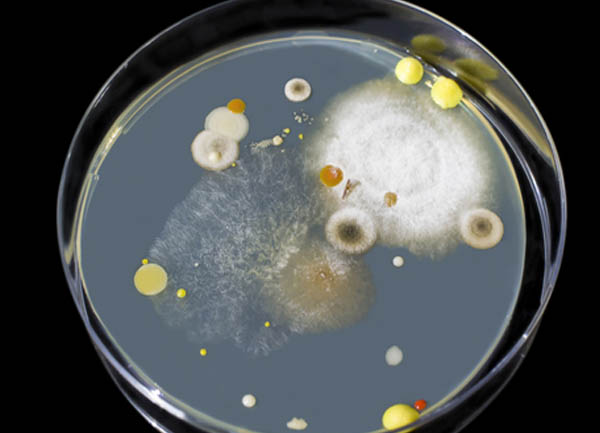
Testing Mold

Jul 17, 2023
ABOUT MOLDEXPERT
We are Singapore’s top specialist Mold Treatment Company, providing mold removal and decontamination services to Commercial, Industrial and residential premises. We aim to protect people from the harmful mold. By providing an extensive choice of high-quality mold cleaning services tailored to our customers, we ensure a high level of hygiene and help in eliminating hazardous situations due to mould and mildew.
Moldexpert certified mold removal Singapore Company, is committed to providing reliable and effective solutions to combat all types of mold issues.
Book a Mold Remediation Service
Our Services
Mold Inspection
Our proficient team conducts meticulous mold inspections to pinpoint the root cause of mold growth and assess the extent of the damage. Our Mold Inspection includes visual inspection, thermal imaging, relative humidity, and temperature.

Mold Testing
Our precise mold testing procedures help identify the specific type of mold present in your property, allowing us to customize our solutions to meet your unique requirements and achieve long-lasting results.
Mold Treatment and Removal
Mould treatment for wall first we Conduct a thorough inspection to identify the extent and source of mold growth. Use moisture meters and thermal imaging to detect hidden mold and moisture issues. Containment. Isolate affected areas to prevent the spread of mold spores during the removal process. Use physical barriers and negative air pressure to contain mold.
Remove contaminated materials such as drywall, insulation, and carpeting. Remove mould from ceiling affected surfaces using specialized equipment and cleaning agents. Apply antimicrobial treatments for bathroom ceiling mold removal to prevent future mold growth. Address moisture issues by repairing leaks, improving ventilation, and using dehumidifiers.
We using industry-approved techniques, we perform thorough mould treatment and removal procedures to ensure the complete eradication of mold from your property, restoring it to a safe and healthy environment.

Mold Cleaning
Mold can aggregate and might be difficult to remove throughout the long term. Mold discharges spores that can reason hypersensitivities. These allergens might be undetectable to the eye however rationale outrageous medical problems can.
Employing industry-leading techniques and eco-friendly products, we swiftly and efficiently eliminate mold from your premises, guaranteeing a safe and healthy environment for you and your loved ones.


Why Choose Us?
Certified Professionals
Our team consists of certified professionals who possess extensive expertise in the latest mold remediation in Singapore methodologies.
Cutting-edge Technology
We leverage state-of-the-art equipment and advanced technology to ensure the most efficient and effective mould removal Singapore treatment process in compliance with government standards.
Comprehensive Solutions
Whether it’s a residential or commercial property, we offer comprehensive approved mold remediation solutions tailored to your specific needs in Singapore.
Customer Satisfaction
We prioritize customer satisfaction and are dedicated to delivering top-notch service that goes beyond the expected standards in Singapore.
Our Recent Mold Cleaning Results


moldexpert has a professional team of mold removal in Singapore experts. We have extensive knowledge of mold cleaning in residential, commercial and offices.
Mold Removal FAQ
How long does the mold removal process take?
The duration of the mold removal process depends on the extent of the mold growth and the size of the affected area. A minor mold problem may take a 3 to 4 hours to address, while more extensive issues could take a day or more.
Can I stay in my home during the mold removal process?
In some cases, you may be able to stay in your home during the mold removal process, especially if the affected area is contained and the mold is not widespread. However, for larger infestations or if anyone in your household has health issues, it may be safer to stay elsewhere temporarily.
How do you prevent mold from coming back?
Preventing mold from returning involves addressing the source of moisture. This may include repairing leaks, improving ventilation, using dehumidifiers, and ensuring that all areas are properly dried and treated with antimicrobial agents.
Will my insurance cover mold removal?
Insurance coverage for mold removal varies depending on your policy and the cause of the mold. Some policies cover mold removal if it is a result of a covered peril, such as water damage from a burst pipe. It’s important to review your policy and consult with your insurance company to understand your coverage.
Is mold removal safe?
Professional mold removal is safe when performed by trained and certified technicians. Moldexpert follows industry standards and safety protocols to protect both occupants and workers during the mould removal services in Singapore process.
Does the warranty cover mold treatment?
Yes we give 3 months warranty.
Don’t compromise on the safety of your property or your well-being. Get in touch with Mold Expert today for reliable and professional certified mold specialist in Singapore service. Our experts are prepared to assist you and restore your property to a safe and mold-free environment, fully compliant with Singapore regulations.
Call us at 6980 3512 or email us at Sales@moldexpert.com.sg to schedule a consultation or to learn more about our professional mold treatment and removal services in Singapore. Let us help you create a healthy and mold-free living or working space.
Testimonials
Very highly recommended!! MOLDEXPERT is fantastic! It is really nice to see that they are still company like this! Professional, knowledgeable and sincere with a first-class Mold Removal Service.
A very thorough evaluation for mold was conducted by the MOLDEXPERT team inside and with the exterior of the house, including some air and tape samples. Our home is rather large and the mold specialist, spent at least five hours plus with the physical evaluation. All facets of their service were excellent.